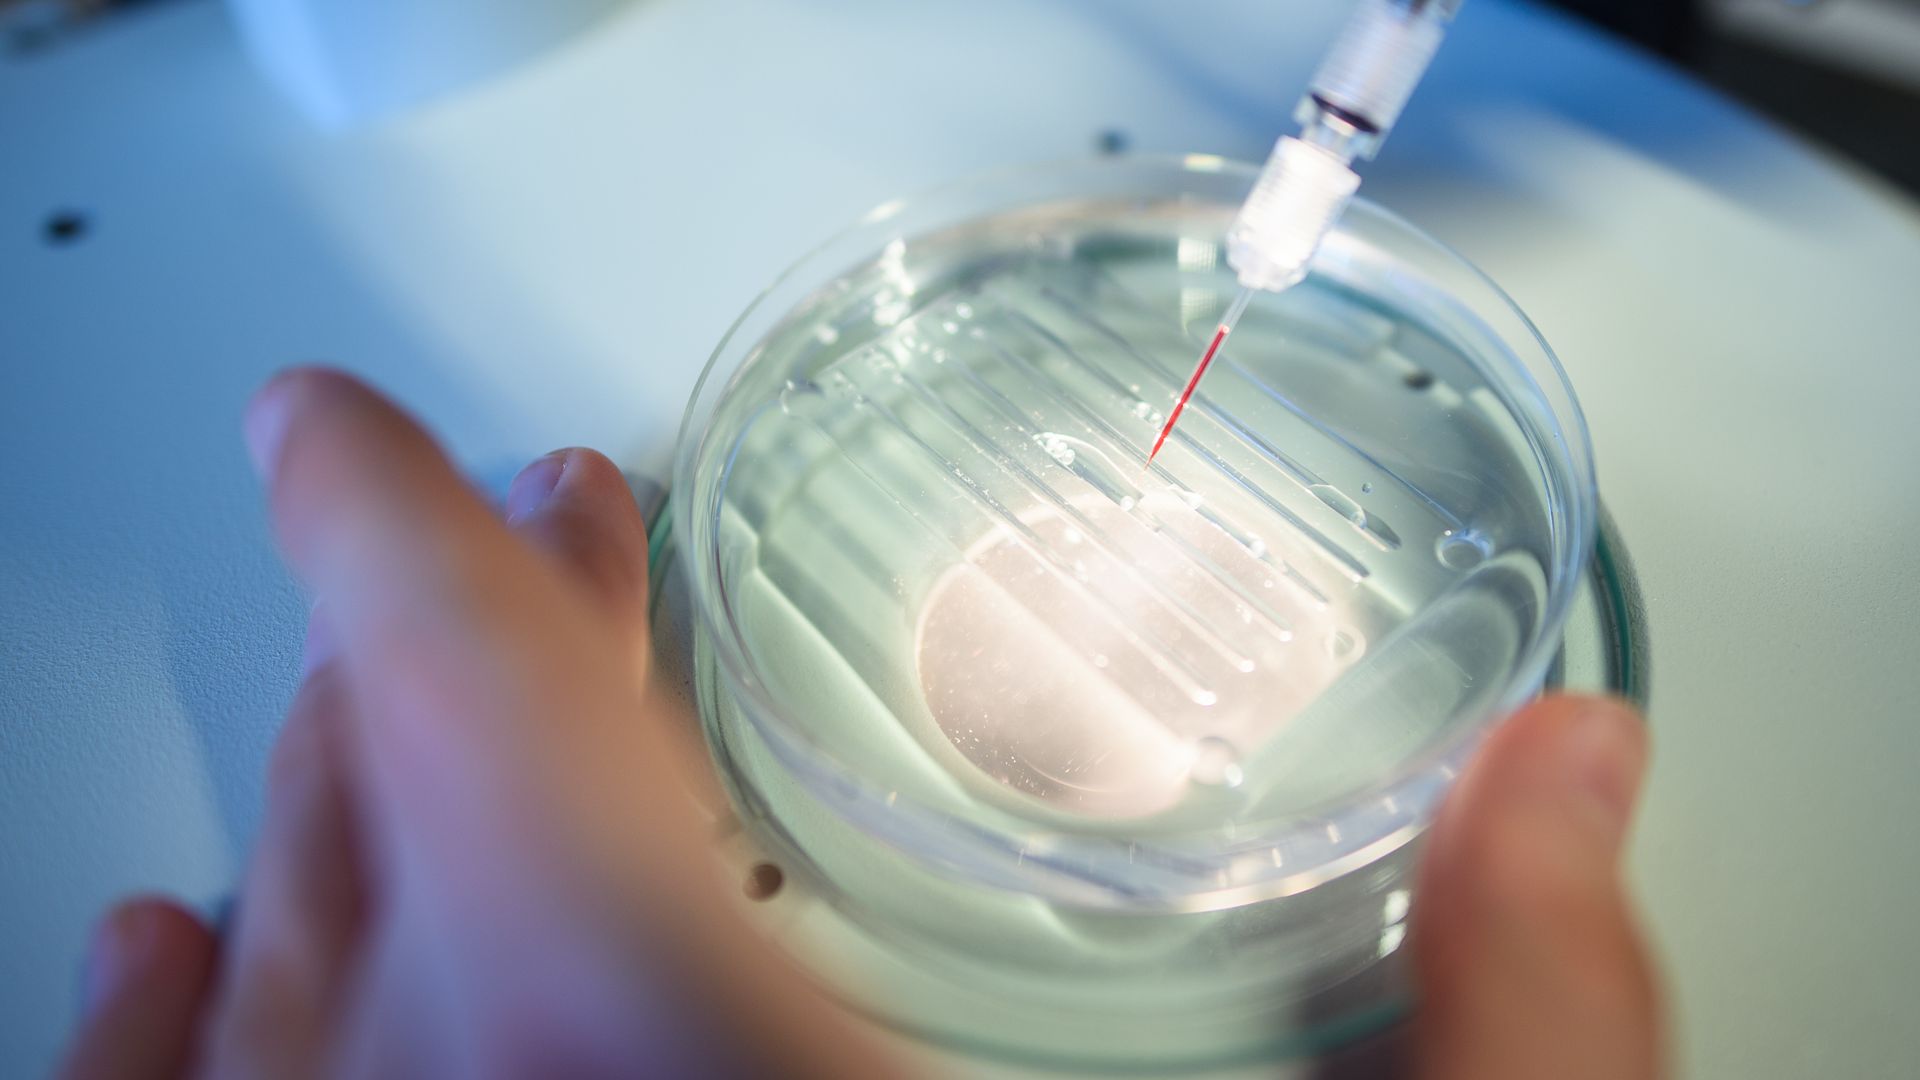
A researcher performs a CRISPR/Cas9 process at the Max-Delbrueck-Centre for Molecular Medicine.

Nov 7, 2019
Doctors safely use CRISPR on cancer patients
Add Axios as your preferred source to
see more of our stories on Google.
A researcher performs a CRISPR/Cas9 process at the Max-Delbrueck-Centre for Molecular Medicine. Photo: Gregor Fischer/picture alliance via Getty Images
